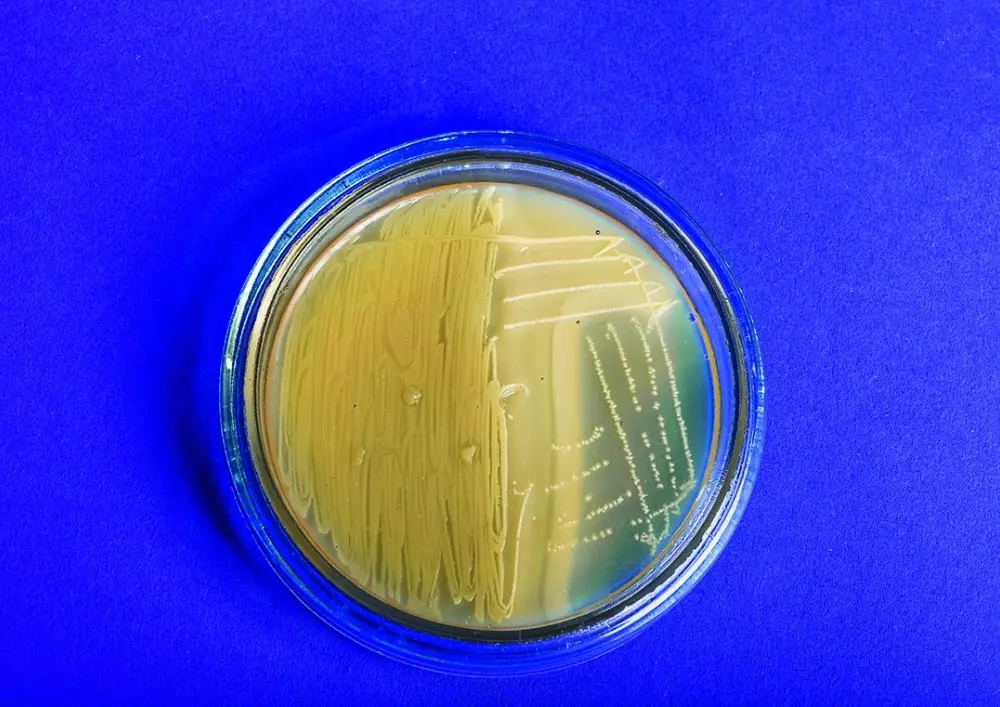

Styczeń 2019
Tematem numeru czterdziestego ósmego numeru „Forum Stomatologii Praktycznej” jest relokacja dna ubytku z zastosowaniem żywicy kompozytowej przy rekonstrukcjach pośrednich. Zachęcamy do zapoznania się z obszernym opracowaniem na ten temat z bogatą dokumentacją zdjęciową.
Tym razem skupiamy się na następujących zagadnieniach:
- Wsparcie ortodontyczne a choroby przyzębia
- Ostateczne płukanie kanałów korzeniowych
- Żywica kompozytowa wykorzystana w zabiegu relokacji dna ubytku
Żywica kompozytowa wykorzystana w zabiegu relokacji dna ubytku
Obecnie możliwe jest leczenie nawet poważnie zniszczonych zębów za pomocą stomatologii rekonstrukcyjnej, wykorzystującej materiały o wysokiej przezierności. Materiały kompozytowe oraz ceramika łączona adhezyjnie z tkankami zęba mogą być stosowane w technikach małoinwazyjnych. Jaki pisze lek. stom. Adam Romaniuk-Demonchaux „stabilne i przewidywalne połączenie pomiędzy tkankami zęba z materiałem kompozytowym czy ceramiką umożliwia realizowanie na szeroką skalę addycyjnych procedur klinicznych. Fundamentem tego protokołu postępowania jest adhezja”. Sprawdź, w jaki sposób wykorzystana została w tym przypadku żywica kompozytowa oraz co wiąże się z tym postępowaniem.
Ostateczne płukanie kanałów korzeniowych
W aktualnym numerze skupiamy się na ostatecznym płukaniu kanałów korzeniowych. Podpowiadamy, jakie środki płuczące najlepiej stosować oraz poruszamy kwestię warstwy mazistej, która wciąż budzi liczne kontrowersje. Wskazujemy, że przede wszystkim należy stosować kilka środków płuczących łączonych w jedną koncepcję terapuetyczną – zwykle wykorzystuje się następujące środki: 2–5-procentowy roztwór podchlorynu sodu (NaOCl), 17-procentowy roztwór wersenianu sodu (EDTA) lub roztwór kwasu cytrynowego. Niektórzy autorzy polecają również stosowanie chlorheksydyny. Środki te wprowadza się za pomocą narzędzi, takich jak strzykawki Luer-Lock oraz igieł endodontycznych. W tekście omawiamy również sposoby aktywacji środków płuczących za pomocą fal ultradźwiękowych. Wskazujemy również na fakt, że ostateczne płukanie kanałów korzeniowych powinno obejmować usunięcie warstwy mazistej, która jest siedliskiem drobnoustrojów i bakterii.
Wsparcie ortodontyczne a choroby przyzębia
Kolejnym ciekawym tematem poruszanym na łamach naszego czasopisma jest wsparcie ortodontyczne w leczeniu choroby przyzębia. Dr n. med. Agnieszka A. Pawlik oraz lek. stom. Magdalena Mazur podkreślają, że interdyscyplinarne podejście do leczenia schorzeń przyzębia obejmujące korektę wad zgryzu pozwala na poprawę stanu wszystkich tkanek przyzębia. Wskazują one, że założenie aparatu ortodontycznego u pacjenta ze zredukowanym przyzębiem jest bezpieczne, jeśli odbywa się w fazie remisji choroby przyzębia, wszystkie działania są ściśle nadzorowane a sam pacjent jest zaangażowany w leczenie oraz troskę o jak najlepszą higienę jamy ustnej.
- Krystyna Brońska
- 3 lutego 2019
- Adam Romaniuk-Demonchaux
- 3 lutego 2019